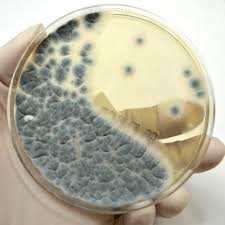
<p>Penicillium Mold (Asexual)</p>
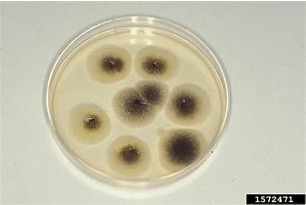
<p>Aspergillus Mold (Asexual)</p>

Microbiology Lab Practical Midterm
1/68
There's no tags or description
Looks like no tags are added yet.
Name | Mastery | Learn | Test | Matching | Spaced | Call with Kai |
|---|
No analytics yet
Send a link to your students to track their progress
69 Terms
Bright field Microscope
A type of microscope that allows light rays to pass directly to the eye and is most commonly used by students
Ocular
This part of a bright field microscope is known to be the eyepiece that consists of two or more internal lenses with a usual magnification of 10x; binocular

Objective Lens
This part of the bright field microscope has magnifications of 4x(rapid scan), 10x(low power), 40x(high-dry), and 100x(oil immersion)

Nosepiece
This part of the bright field microscope allows for the objective lens to be rotated into position over the slide
Total Magnification
This process is determined by multiplying the power of the objective lens times the power of the ocular lens used
Condenser
This part of the bright field microscope is located under the stage which collects and directs the amount of light from the light source to the slide being studied

Diaphragm Control
This part of the bright field microscope is located within the condenser which regulates the amount of light that reaches the slide; can either be controlled by turning a knob or a lever

Course Adjustment Knob
This part of the bright field microscope is found on the side of the microscope which moves the slide up and down considerably for better focus; does not get used again after 10x objective lens
Fine Course Adjustment
This part of the bright field microscope is found on the side of the microscope which moves the slide up and down minimally for finer detail
Resolving Power
The ability of a lens to to completely separate two images in a microscopic field
Steps for Oil Immersion
1.) Make sure slide is in focus under microscope
2.) Turn the nose piece halfway between the 40x and 100x objective lens
3.) Apply a drop of oil to the slide
4.) Fully rotate the nosepiece until the 100x objective lens rests on top of the slide
5.) Adjust the fine adjustment knob
Care of the Microscope
Use both hands to transport the microscope with one supporting the bottom and the other supporting the neck
Use lens paper only to wipe the ocular lens, objective lens, condenser
Microorganisms (Microbes)
All organisms that are too small to be seen without a microscope
Prokaryotes
Eukaryotes
Acellular
Prokaryotes
Single-celled organisms characterized by the lack of a nucleus and membrane-bound organelles
Bacteria (Cyanobacteria)
Archaea
Eukaryotes
Multi-celled organisms containing a membrane-bound nucleus and organelles like mitochondria
Algae
Fungi
Protozoa
Helminths
Acellular
Entities lacking a cellular structure, meaning they are not composed of cells, possess no organelles, ribosomes, or plasma membranes
Viruses
Viroids
Prions
Prokarya-Cyanobacteria
Formerly known as blue-green algae, aquatic, photosynthetic, no motility(glide with water currents), reproduce asexually (binary fission), and do not cause infectious disease
Anabaena
Oscillatoria
Anabaena
This cyanobacteria formulates a bead-like chain

Oscillatoria
The cyanobacteria formulates long, skinny rectangular strips

Eukarya-Protists-Algae (Green Algae)
This type of microbe is eukaryotic ranging from unicellular to giant multicellular organisms, aquatic, photosynthetic (chloroplasts), motile by flagella, mostly produces asexually, and does not cause infectious disease
Euglena
Volvox
Spirogyra
Flagella
Green algae is motile through the use of this structure
Euglena
This green algae is an elongated oval shape with internal organelles present

Volvox
This green algae has a large, circular shape with internal organelles present

Spirogyra
This green algae is shaped into long rectangles, with a spiral pattern running through it

Protozoa (Ciliates)
This microbe is eukaryotic but is unicellular, lacks a cell wall, thrives in moist environments, heterotrophic, motile by cilia pseudopodia or flagella, mostly reproduces asexually (mitosis), and most do not cause disease
Paramecium
Stentor
Amoebae
Flagellates
Apicomplexans
Heterotrophic
An organism that cannot produce its own food, obtaining energy and organic carbon by consuming other organisms, plants, or organic matter.
Paramecium
This protozoa (ciliate) are slipper shaped and travel using cilia

Cilia
Hair-like, microtubule-based organelles on eukaryotic cells that facilitate locomotion, sensory functions, and fluid movement
Flagella
Long, whip-like appendages in microbiology that function as rotary motors, enabling bacterial motility for navigating environments, seeking nutrients, and enhancing virulence
Stentor
This protozoa can either look like venus fly traps or trumpet shaped, are motile using cilis

Amoebae
A blob-like shape, uses pseudopodia for motility

Pseudopodia
Temporary cytoplasmic extensions used for locomotion and feeding (phagocytosis)
Fungi
Eukaryotic ranging from unicellular (yeasts) to filamentous (molds) tp multicellular (mushrooms), heterotrophic, have a cell wall, reproduce asexually (spores) or sexually (zygospore)
Mold Characteristics
Hyphae
Mycelium
Septa
Hyphae
Long, branching, filamentous structures that form the main vegetative growth of fungi

Mycelium
Mass of hyphae

Septa
Thin, dividing walls or membranes that separate cavities, tissues, or cells within organisms, providing structural support, compartmentalization, and regulation of material flow

Asexual Reproduction
Mitotic division of parental cells
Sexual Reproduction
Union of two parental nuclei followed by meiosis
Sporangium
This mode of asexual production is a sac-like structure containing spores
Rhizopus
Aspergillus

Phalospores
This mode of asexual reproduction is flask-shaped containing spores
Penicillium

Zygospore (Sexual)
This mode of sexual reproduction is a bow-like structure with a zygote in the middle
Rhizopus


Rhizopus Mold (Asexual)
This type of fungi is lollipop shaped and is asexual; reproduce through sporangiospores


Rhizopus Mold (Sexual)
This type of fungi is similarly shaped as round in the center with two tails on each end; reproduce through zygospores

Penicillium Mold (Asexual)
This type of fungi are finger-like shaped; reproduce through phaliospores

Aspergillus Mold (Asexual)
This type of fungi has a stalk followed by a spherical tip that’s mop-like; reproduce from sproangiospores

Yeast (Fungi)
Unicellular, some can form pseudohyphae
Blastospores
asexual fungal spores produced by budding; small daughter cell (bud) grows directly out of a larger mother cell.
Pseudohyphae
Chains of elongated yeast cells that remain attached after budding, forming filaments with distinct constrictions

Candida
Long filaments with budding all around, reproduce through asexual budding

Bacilli
Round or tapered ends
Singular or in chains
Can be motile with flagella

Strepto
Bacteria shape is in a chain

Staphyl
Bacteria shape is in clusters

Cocci
spherical bacteria shape that can be presented in chains, clusters(diploid, tetrads, many)
Not motile —> no flagella

Spirals
Curved rods
Slender = spirochetes
Thicker = spirilium
Comma shaped rod = vibrio
Can be motile with flagella

Turbidity
The cloudiness or haziness of a liquid culture, indicating the presence of bacteria cells
Colony
A visible cluster of microorganisms, often originating from a single cell, growing on solid medium
Aseptic Technique
Set of procedures performed to minimize contamination by microbes/pathogens
Work area disinfection
loop and needles
culture tube flame and inoculation
petri plate inoculation
Smear Preparation Purpose
Adhere cells to slide so they do not get washed off by staining steps
Does not change morphology of cells
Must be thin enough to allow light to penetrate, allow visualization of individual cells, not allow for trapping of dye
Smear Preparation Steps
1.) Prepare slides (label + draw target circle)
2a.) From liquid —> place one loopful on slide and spread over target circle
2b.) From solid(plate, slant, solid surface) —> place one loop of water on slide and then place small amount of culture in water on slide and spread over target circle
3.) Allow slide to air dry
4.) Pass slide through flame 3-5 times
kills organisms
fixes organism to slide
Simple Stain Purpose
Single, positively charged stains adhere to negatively charged cells
Ex: methylene blue, fuchsin, crystal violet
Determine c\shape of bacteria
Arrangement of bacteria
Presence of granules
Simple Stain Steps
1.) Use a prepared smear
2.) Add simple stain to sample
3.) Incubate 30 seconds to 2 minutes
4.) Remove excess stain with water
5.) Blot water with bibulous paper
6.) Observe under microscope
Spore Staining Steps
1.) Prepare smear
2.) Cover with paper towel soaked in malachite green dye
3.) Steam over boiling water for 5 minutes
4.) Counterstain with safranin
*Malachite green retained in endospore, vegetative/growing cells stain red/pink with safranin
Acid Fast Bacteria
This type of bacteria contains a high lipid content in their cell wall (waxy) which affects staining abilities
-TB, leprosy
Acid Fast Staining Method
1.) Prepare heat fixed smear
2.) Cover smear with carbolfuchsin for 5 minutes
3.) Wash with water, shake excess water
4.) decolorize with acid-alcohol
5.) Rinse off decolorization after 10 seconds briefly with water
6.) Counterstain with methylene blue
*Acid-fast bacteria will stain red/pink and non-acid bacteria will stain blue
Meningitis
This disease can be found in negative stains
Gram Stain Purpose
The purpose of this stain is to to rapidly classify bacteria into two broad categories based on the structural differences in their cell walls. It provides immediate information on bacterial shape, size, and cell wall composition, allowing clinicians to guide early, targeted antibiotic treatment for infections.
Gram Stain Steps
1.) Prepare heat fixed smear
2.) Apply crystal violet for 1 minute
3.) Wash until stain is removed and shake off excess water
4.) Apply gram’s iodine for 1 minute
5.) Wash off using water
6.) Decolorize for 10 seconds
7.) Wash
8.) Apply safranin for 1 minute
9.) Wash
10.) Blot dry with bibulous paper
11.) Observe
C. diff
A gram stain is used to test for this disease